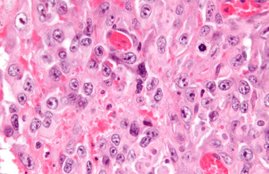

Delhi AIIMS: आरोपी डॉ रॉय का कहना है, “मैं इस पर कोई टिप्पणी नहीं कर सकता और जांच खत्म होने…

AIIMS Recruitment 2022: कैंडीडेट्स का चयन इंटरव्यू के आधार पर होगा। मिले हुए आवेदन में से ही कैंडीडेट्स को इंटरव्यू…

सोमवार को सरकारी अस्पतालों के रेजिडेंट डॉक्टरों ने नीट-पीजी 2021 की काउंसलिंग में हो रही देरी को लेकर मौलाना आजाद…

AIIMS Recruitment 2021: आवेदन विज्ञापन जारी होने के 30 दिन के अंदर तक किया जा सकता है। आवेदन करने के…

AIIMS Recruitment 2021: इस भर्ती के तहत प्रोफेसर, एसोसिएट प्रोफेसर, एडिशनल प्रोफेसर और असिस्टेंट प्रोफेसर के रिक्त पदों को भरा…

AIIMS Raipur Recruitment 2021: इन पदों पर चयनित उम्मीदवारों को 7th CPC के अनुसार 67700 रुपए वेतनमान दिया जाएगा।

AIIMS Recruitment 2021: इच्छुक और योग्य उम्मीदवार इन पदों के लिए एम्स, जोधपुर की वेबसाइट aiimsjodhpur.edu.in के माध्यम से आवेदन…

Delhi-AIIMS Fire: दिल्ली एम्स में सोमवार को सुबह करीब 5 बजे आग लगने से हड़कंप मच गया। इसके बाद न…

AIIMS Chhattisgarh Recruitment 2021: लेक्चरर के पद पर आवेदन करने के लिए उम्मीदवारों की अधिकतम आयु 50 वर्ष निर्धारित है।

दिल्ली एम्स के आरडीए ने शिकायत में यह भी कहा कि पूरे परिसर में गार्ड नहीं है। यह भी एक…
कैंसर की एक घातक किस्म यानी सारकोमा से पीड़ित मरीजों के हाथ-पैर कटने से बचाने के लिए एम्स के डाक्टरों…













